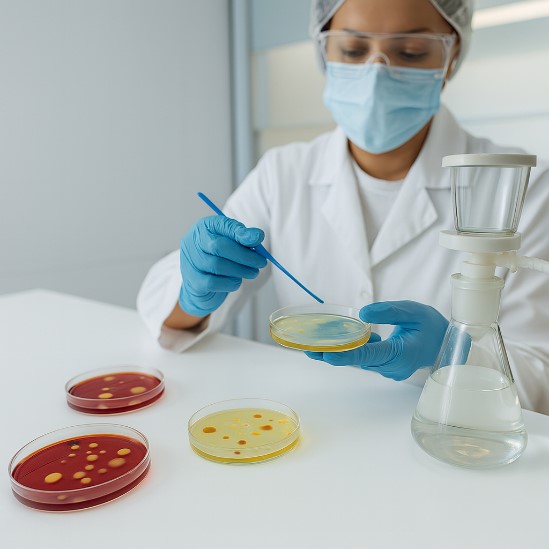
شمارش کلی پاتوژن های میکروبی

صفحه اصلی
مرکز اموزش و پژوهش بیماری های پوست ، دانشگاه علوم پزشکی تهران
از سال 1399 تاکنون این شرکت زیر مجموعه مرکز رشد گیاهان دارویی مشتقر در دانشگاه علوم پرشکی تهران میباشد .
بررسی بی خطری و کارایی کلیه فراورده های دارویی،ارایشی، بهداشتی و مکمل های پوستی - تنها مرجع مورد تایید سازمان غذا و دارو

بررسی پرونده محصولات
بررسی و تکمیل مستندات رگولاتوری، برای شرکتهای وارد کننده و تولید کننده محصولات پوستی و آرایشی…
ادامه مطلب
خدمات کمک تشخیصی
ارائه دهنده خدمات کمک تشخیصی در جهت تشخیص و پیگیری بیماری های پوست و مو به…
ادامه مطلب
ارزیابی های آزمایشگاهی
آزمایشگاه کنترل میکروبی فرآورده های دارویی، آرایشی و بهداشتی آزمایشگاه فیزیکوشیمیایی
ادامه مطلب
ارزیابی های بالینی
کلیه آزمون های ایمنی و بالینی روی داوطلبین انسانی و با کمترین ضریب خطا، مانند:
ادامه مطلب
- fArimA_DL_28
- ارسال دیدگاه
معرفی خطمشیها و رویهها برای استارتآپها
لورم ایپسوم متن ساختگی با تولید سادگی نامفهوم از صنعت چاپ و با…
ادامه مطلب
شوخی در محل کار باعث ایجاد مشکل در کسب و کار شما می شود؟
لورم ایپسوم متن ساختگی با تولید سادگی نامفهوم از صنعت چاپ و با…
ادامه مطلب
روش های درک بیشتر مربیگری اجرایی و شناخت عوامل آن
لورم ایپسوم متن ساختگی با تولید سادگی نامفهوم از صنعت چاپ و با…
ادامه مطلب










